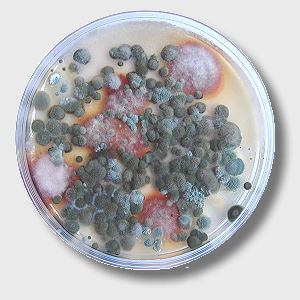
Luftkeime

Raumluft und Arbeitsplatz
In immer größer werdendem Umfang führen Emissionen aus Baustoffen, Möbeln, Textilien, etc. in Innenräumen zu gesundheitlichen Beschwerden.
Hierfür kann eine Vielzahl von verschiedenen chemischen Substanzen aber auch eine mikrobielle Belastung verantwortlich sein.
![]() |
Holzschutzmittel (z.B. Pentachlorphenol (PCP) und Lindan) |
![]() |
Formaldehyd |
![]() |
Polychlorierte Biphenyle (PCB) |
![]() |
Polycyclische Aromatische Kohlenwasserstoffe (PAK) |
![]() |
Asbest |
![]() |
VOC (von „Volatile OrganicCompounds“) flüchtige organischen Verbindungen |
![]() |
MVOC (von "Microbial Volatile OrganicCompounds") flüchtige organischen Verbindungen mikrobiologischen Ursprungs |
![]() |
Lösemittel z.B. BTEX |
![]() |
Kontaktproben auf Bakterien, Schimmelpilze und Hefen |
![]() |
Gesamtzahl der kulivierbaren Schimmelpilzsporen in Raumluft |
Keime aus 100l Luft auf Nährboden nach einer Woche Bebrütungszeit